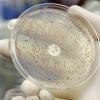
Биологи научили бактерии синтезировать пластмассу

отметили
24
человека
в архиве
отметили
85
человек
в архиве
Рекорд роста цен на нефть: за день цена выросла на 25$!
 lenta.ru
lenta.ru
Цена на нефть повысилась в ходе торгов на Нью-Йоркской товарной бирже на 25 долларов, установив абсолютный рекорд роста в течение одного торгового дня. Незадолго до окончания сессии нефтяные котировки вплотную приблизились к отметке 130 долларов за баррель.
проблема (2)
отметили
63
человека
в архиве
Роспотребнадзор приостановил продажу 25 тонн американской курятины
 lenta.ru
lenta.ru
В Алтайском крае приостановлена продажа 25 тонн американской курятины, сообщил глава Роспотребнадзора Геннадий Онищенко.
По его словам, управление ведомства по Алтайскому краю произвело проверку на предприятиях, в ходе которой был выявлен ряд нарушений. В частности, в 22 случаях установлено...
проблема (1)
отметили
101
человек
в архиве
Страны Пердсидского залива вводят единую валюту
 mignews.com
mignews.com
5 стран Персидского залива согласовали вопрос об учреждении валютного союза и принятии единой денежной единицы.
В заседании, которое состоялось на прошлой неделе в среду, 17 сентября, министры финансов государств, входящих в Совет сотрудничества стран Залива (Бахрейн, Кувейт, Катар, Саудовс...
отметили
48
человек
в архиве
Статья «Как умирают софтверные компании»
 vadda.livejournal.com
vadda.livejournal.com
Среда, в которой талантливые программисты цветут и пахнут, убивает всяческого рода управленцев и маркетологов — и наоборот. Программирование — это Большая Игра. Она захватывает тебя, твое тело и душу. Как только ты увлекаешься ею — для тебя больше не существует ничего. Когда ты выползаешь на свет бо...
проблема (1)
отметили
124
человека
в архиве
Вьетнам отменяет визы для россиян с января 2009 года
 ru.reuters.com
ru.reuters.com
Власти Вьетнама отменят визы для россиян, приезжающих в страну на срок менее чем 15 дней, с начала следующего года, сообщила в понедельник газета Tuoi Tre.
Новые правила коснутся владельцев российских паспортов вне зависимости от цели их визита с 1 января 2009 года, сообщил газете глава одн...
отметили
51
человек
в архиве
Биологи научили бактерии синтезировать пластмассу
 membrana.ru
membrana.ru
Одна из самых изученных бактерий — кишечная палочка (Escherichia coli — E. coli), "любимица" микробиологов и один из частых объектов для опытов по генной инженерии, и на этот раз исправно выполнила поставленную задачу. Разумеется, после того как специалисты из Genomatica немного поколдовал...
отметили
60
человек
в архиве
Во взорванном отеле Marriott должен был обедать президент Пакистана
 top.rbc.ru
top.rbc.ru
В пакистанском отеле Marriott, возле которого было взорвано не менее тонны взрывчатки, должны были обедать президент страны Асиф Али Зардари и премьер-министр Юсуф Раза Джилани, однако в последний момент они изменили свое решение. Об этом сообщил министр внутренних дел Пакистана Рехман Малик.
Пр...
проблема (1)
отметили
85
человек
в архиве
Чубайс главный по нанотехнологиям
 lenta.ru
lenta.ru
"Бывший председатель правления РАО "ЕЭС России" Анатолий Чубайс назначен гендиректором госкорпорации "Роснано". Указ об этом подписал президент России Дмитрий Медведев, сообщает РИА Новости."
Симптоматично, по моему. ...
отметили
48
человек
в архиве
Последние соки - Финансовый кризис отправил инвестиционные банки Уолл-стрит в историю
 lenta.ru
lenta.ru
Эра инвестиционных банков в США началась 75 лет назад, когда Конгресс провел юридическое разделение финансовых организаций на коммерческие и инвестиционные. Изначально инвестиционные банки занимались торговлей ценными бумагами за фиксированную комиссию, которая приносила им достаточно высокий доход....
отметили
65
человек
в архиве
Госдепартамент США счел Россию слишком слабой для новой холодной войны
 lenta.ru
lenta.ru
Заместитель помощника госсекретаря США по европейским и евразийским делам Мэтью Брайза в интервью азербайджанскому телеканалу ANS заявил, что Россия слишком слаба для новой холодой войны с США, сообщает "Интерфакс".
Брайза также выразил надежду, что "Россия рано или поздно по...
проблема (3)
отметили
104
человека
в архиве
Министр культуры и туризма Украины Василий Вовкун о русском языке «Ви не будете розмовляти собачою мовою!»
 tinyurl.com
tinyurl.com
Русскоязычных на Украине приравняли к собакам.
«Премьер проводила закрытое заседание по вопросам подготовки к Евро-2012. Присутствовали все члены КМУ, губернаторы, мэры. Закончив выступление, Тимошенко предложила присутствующим высказаться. Я вышел к микрофону, заговорил по-русски. Сидевший возл...
проблема (8)
отметили
112
человека
в архиве
Яндекс стал стратегическим активом
 smoney.ru
smoney.ru
Недавно один высокопоставленный чиновник заявил на закрытой встрече с журналистами, что Кремль расценивает «Яндекс» как стратегический медийный актив, этакое суперСМИ, которое необходимо сохранить в «правильных» руках.
проблема (1)
отметили
45
человек
в архиве
Work to Stop Human Rights Abuses! $1375-$2175/month
 newyork.craigslist.org
newyork.craigslist.org
Известная всем как бы общественная организация Amnesty International предлагает за денежку стоять с плакатом перед зданием ООН и изображать общественный протест. Можно на полставки.
проблема (2)
отметили
112
человека
в архиве
Гопник нарвался на пулю в питерском метро
 fontanka.ru
fontanka.ru
… Однако как удалось выяснить милиционерам, картина произошедшего была несколько иная. По предварительным данным, молодой человек вместе с еще тремя парнями и одной девушкой приставали к пассажирам метро.
Одного человека они, якобы, даже избили, а затем накинулись на мужчину — выходца с Кав...
отметили
53
человека
в архиве
Московские власти вводят новые правила пользования метро
 rian.ru
rian.ru
Новые правила пользования столичной подземкой регламентируют пользование проездными билетами и вводят некоторые новые обязанности пассажиров.
Отныне пассажиры метро будут обязаны предъявить проездной билет работникам метро по требованию. Такая мера стала необходимой из-за того, что после появлен...
проблема (2)
отметили
63
человека
в архиве
Саакашвили расскажет завтра в ООН про этническую чистку грузин
 rosbalt.ru
rosbalt.ru
Президент Грузии Михаил Саакашвили 23 сентября выступит на 63-й сессии Генеральной Ассамблеи ООН и расскажет об августовских событиях в Грузии.
В частности, передает «Интерпрессньюс» со ссылкой на грузинских экспертов и политиков, президент поведает «о проведенной Россией этнической чистке ...
проблема (3)
отметили
57
человек
в архиве
В некоторых банках немножечко остановились платежи
 vedomosti.ru
vedomosti.ru
Узнав о финансовом кризисе, вкладчики потянулись в банки. Забрать свои деньги сразу получается не у всех.
проблема (3)
отметили
10
человек
в архиве
отметили
41
человек
в архиве
Космический аппарат Pamela обнаружил темную материю в центре Млечного пути
 cybersecurity.ru
cybersecurity.ru
Европейские астрономы при помощи космической лаборатории Pamela обнаружили облако из темной материи, расположенное в непосредственной близости от центра Млечного пути.
отметили
50
человек
в архиве
SlotMusic - новый музыкальный формат
 cybersecurity.ru
cybersecurity.ru
Крупный мировой производитель съемных карт памяти компания SanDisk в сотрудничестве с четырьмя основными международными звукозаписывающими компаниями сегодня анонсируют новый цифровой музыкальный формат, получивший название SlotMusic.
отметили
80
человек
в архиве
News2 vs Smi2: лицом к лицу
 koreps.ru
koreps.ru
Я провел сравнение двух самых популярных новостных социальных сетей — News2 и СМИ2. Сделал это по одной простой причине — скоро выйдет в свет конкурент этих соц. сетей, говорить о котором мне пока нельзя. Интересно посмотреть на ситуацию до и после него. Есть еще Newsland, но его я рассматривать не ...
проблема (3)
отметили
60
человек
в архиве
Вице-президенту США Чейни запретили уничтожать служебные документы
 newizv.ru
newizv.ru
В минувшую субботу судья федерального округа Колумбия Колин Коллэр-Котелли вынесла вердикт по «делу» вице-президента США Ричарда Чейни: он обязан сохранить все служебные документы, имеющие отношение к его работе на высоком государственном посту до того, как выйдет в отставку в январе следующего года...
отметили
92
человека
в архиве
"Евросеть" полностью продана Александру Мамуту
 kommersant.ru
kommersant.ru
100% сотового ритейлера "Евросеть" купила инвесткомпания ANN предпринимателя Александра Мамута. Крупнейший в России сотовый ритейлер с учетом долга оценен в $1,25 млрд.
отметили
67
человек
в архиве
Подтверждено наличие на Марсе объектов неясной морфологии
 rnd.cnews.ru
rnd.cnews.ru
Специалисты Лаборатории реактивного движения NASA в г. Пасадена, а также университета Аризоны представили в открытом доступе изображения поверхности Марса сверхвысокого разрешения, полученных камерой HiRES аппарата Mars Reconnaissance Orbiter в период с 26 апреля по 21 июля 2008 года.
Камер...
проблема (2)